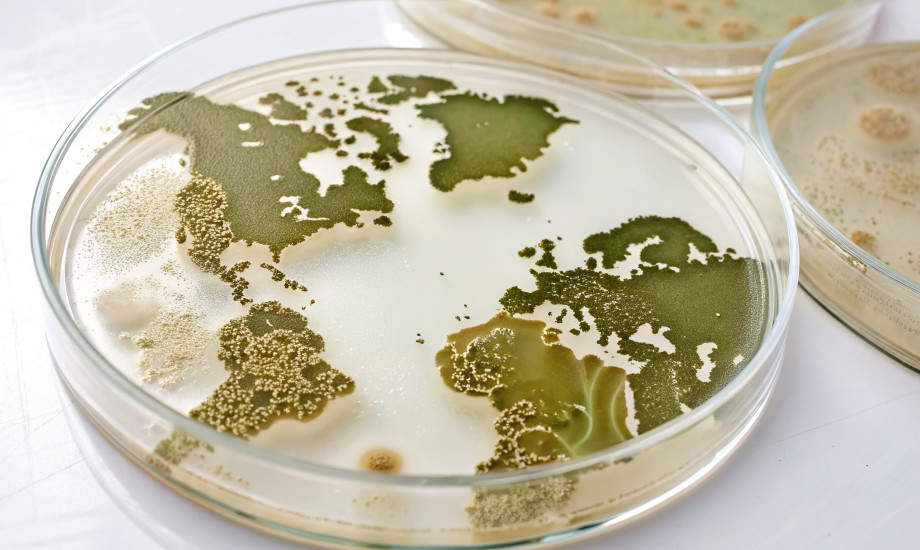

Jede sechste Bakterieninfektion weltweit resistent gegen Antibiotika
Die Weltgesundheitsorganisation (WHO) warnt vor der weltweiten Verbreitung von Resistenzen gegen gängige Antibiotika. Laut einem nun veröffentlichten Bericht der Organisation war 2023 jede sechste im Labor bestätigte bakterielle Infektion bei Menschen resistent.
© Jason/stock.adobe.com
© Jason/stock.adobe.com 





_937553162.jpeg)









HNFOTO_1324222168.jpeg)

Andrea Gaitanides_adobe_1619046331.jpg)
